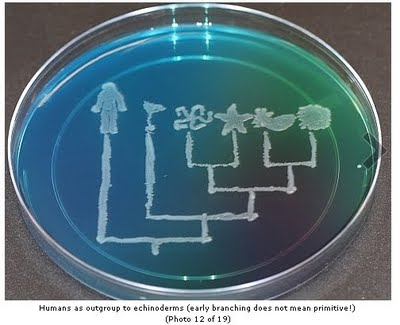

The Art of Mould
By Max Liboiron
I love mould. It is invisible, yet suddenly visible if you let it take over parts of your fridge or bathroom; it can come back from the dead; it is neither animal nor plant. It is mysterious and beautiful. To that end, here are some artists who use mould as a medium and an inspiration.
Italian artist Daniele Del Nero‘s series After Effects uses mould to give a slow and plodding life to miniature models he makes out of black paper. He writes, “My purpose is to talk about the sense of time and destiny of the planet after the human species, through the sense of restlessness which abandoned buildings are able to communicate.”
Stacy Levi makes site-specific work that melds the environment, science, and visceral reactions. Her Mold Garden was created by sandblasting an image of mould onto glass, then allowing mould to grow in the miniature crevasses of the glass, making a double macro-micro portrait.
English textile artist Elinart sells her fabric pieces on Etsy. She makes jewelery, modifies handbags and wallets, and creates stand-alone and wall-hung pieces that are soft, textured, domestic and beautiful. Her descriptive tagline: “Crochet lichen and mould.” Images of her work are on Flickr.
C.L. Frost photographs everyday objects and creates digital collages. The photography caught the attention of FridgeFungus.com, a website that “celebrates the artful and awful nature of food gone bad.” There are some truly spectacular images on the site, including the one above. This particular specimen is both celestial and microcosmic simultaneously.
Polona Tratnik used scrapings from her own body to create, Microcosm, an installation that blurs the lines between inside and outside, and bodily sovereignty. She writes: “In the new environment micro organisms that originate from the body begin to live autonomous lives. Thus an invisible inside becomes visibly revealed. It also becomes a part of the external world, with which our body is coming in contact. A part of a body has actually seceded and become an other and foreign to the body. Huge quantities of micro organisms become a threat. A dangerous environment has arisen, from which our body often cannot protect itself.”
What unites this art, beyond its literal media, is that each flirts with the micro and the macro view, life-sized and miniature scales. And each blurs the lines between living and dead, symbiosis and disease, inside, outside and “out there.” This mirrors the flip flop of repulsion and beauty of the material.
Back when I worked in a laboratory, we used to grow Valentine’s Day cards out of a harmless pink mould. A website called Microbial Art documents the work of various microbiologists and biology labs that make bacteria drawings, living pictures, “bioglyphs” and “Bacteriograms.” If you are interested in trying your hand at a mould art, you can try Mold Garden, a microbiology science primer for kids. A wonderful world awaits you in your own fridge.
A note on Mould vs Mold: Mold is the American spelling for all senses of the word meaning, among other things, (1) a frame for shaping something, (2) to shape in a mold, and (3) any of various fungi that commonly grow on organic matter and are often associated with decay. Mould is the British spelling. American English has no mould, and British English has no mold.